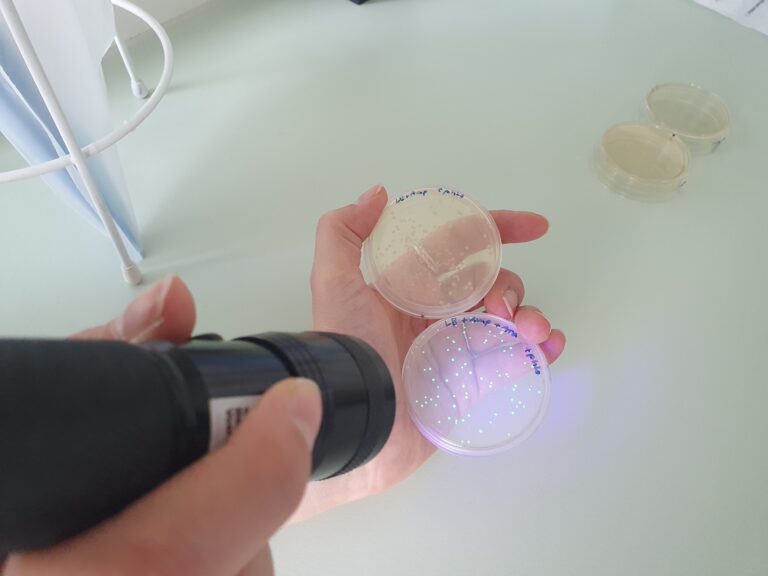

Am 10.10.2023 besuchte die Klasse 13 im Rahmen des Biologieunterrichts das Gläserne Labor Berlin-Buch und absolvierte dort einen vierstündigen Laborkurs zum Thema „Klonierung – Restriktionsenzyme und Transformation“. Ziel war es, mithilfe molekularbiologischer Methoden gentechnisch modifizierte Bakterien zu erzeugen, die aufgrund der Expression eines grün-fluoreszierenden Proteins (GFP), welches natürlicherweise in einer Tiefseequallenart zu finden ist, bei Anregung mit UV-Licht leuchten. Viele Arbeitsschritte sind dabei nötig, bis am Ende leuchtende Bakterienkolonien bewundert werden können. Da der Gesamtprozess den zeitlichen Rahmen des Workshops sprengen würde, wurde ein wenig „getrickst“. Die von uns mit einem GFP-codierenden Plasmid transformierten Bakterien mussten erst über Nacht zu sichtbaren Kolonien heranwachsen. Daher haben wir die Ergebnisse einer Gruppe vom Vortag ausgewertet, die aber – wie hoffentlich auch wir – beste Arbeit geleistet und leuchtende Kolonien erzeugt haben.
Vielen Dank an das Team des Gläsernen Labor Berlin-Buch für den kurzweiligen und lehrreichen Workshop!